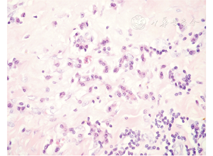

通过报道少见的IgG4相关性心包炎并进行文献复习,分析该病的临床表现和预后。
报道一例IgG4相关性心包炎,并以"IgG4"和"pericarditis"检索PubMed进行文献复习。
本例患者经过临床表现、血清学检查和影像学检查,确诊为IgG4相关性心包炎。IgG4相关性心包炎的临床表现多样,多数经手术病理确诊,对激素治疗反应良好。
本病临床少见,遇到有心包炎临床特征的患者,可行IgG4血清学检测及其他相关腺体疾病筛查,如合并自身免疫相关性疾病应考虑本病可能,早发现,早诊断,早期糖皮质激素治疗可避免手术治疗。

除非特别声明,本刊刊出的所有文章不代表本刊编辑委员会的观点。
IgG4相关性疾病(IgG4 related disease,IgG4-RD)是一种由IgG4淋巴细胞介导的、累及多器官、多系统的慢性进行性自身免疫性疾病。其特点是组织器官中IgG4阳性浆细胞浸润多灶性纤维硬化性改变[1]。目前报道中累及心血管系统的不多,主要有主动脉炎、动脉炎、炎性动脉瘤及动脉周围炎等中大动脉表现[2,3],累及冠状动脉时动脉壁增厚、狭窄及假瘤形成[4,5];如果不合并其他系统受累,IgG4累及心脏的确诊一般只能通过术后病理诊断。既往文献中有若干例IgG4相关性心包炎的报道,现就我们的病例进行分析并做相关文献复习。
方法:以"IgG4"和"pericarditis"为检索词检索Pubmed相关文献,并对相应文献中IgG4相关性心包炎病例进行回顾性分析,检索式:("pericarditis"[MeSH Terms] OR"pericarditis"[All Fields])AND("immunoglobulin g"[MeSH Terms] OR"immunoglobulin g"[All Fields] OR"IgG4"[All Fields]),共检出121篇相关文献,其中20例有心包炎影像表现和(或)临床表现。补充查检索式:("pericardium effusions"[MeSH Terms] OR"pericardium effusions"[All Fields])AND("immunoglobulin g"[MeSH Terms] OR"immunoglobulin g"[All Fields] OR"igg4"[All Fields]),又增加1例患者[6]。
患者男性,47岁,因"腹胀20余天,胸闷、憋气15天"入院。患者入院前20余天无明显诱因出现腹胀,进行性加重,偶伴恶心、呕吐。15 d前出现胸闷、憋气,多于活动后出现,休息后可缓解,同期出现尿量减少、双下肢水肿。7 d前突发憋喘加重,伴大汗,休息后缓解。症状出现后患者饮食差,体重在20 d内增加5 kg,体力明显下降,平地步行200 m即感喘憋。期间予强心、利尿、对症治疗,效果不明显。既往体健。查体:体温36.5℃,脉搏140次/min,呼吸18次/min,血压141/101 mmHg。巩膜轻度黄染,双下肺呼吸音减低,无明显干湿啰音,心律齐,心率140次/min,心音略低,各瓣膜区未闻及明显杂音,腹部膨隆,触诊不满意,叩诊实音,肠鸣音未及,双下肢对称性水肿,达膝上1 cm。实验室检查:白细胞6.6×109/L,血红蛋白121 g/L,血小板258×109/L,总胆红素22.8 μmol/L,直接胆红素10.8 μmol/L,谷草转氨酶32 U/L,谷丙转氨酶22 U/L,肌酐66 μmol/L,血沉7 mm/第1小时,C反应蛋白1.1 mg/dl,转铁蛋白184 mg/dl,补体C3 112 mg/dl,补体C4 21 mg/dl,免疫球蛋白G 1 490 mg/dl,免疫球蛋白M 321 mg/dl,免疫球蛋白A 317 mg/dl,免疫球蛋白G1 10.6 g/L,免疫球蛋白G2 3.85 g/L,免疫球蛋白G3 0.416 g/L,免疫球蛋白G4 0.668 g/L,NT-proBNP 1 137 pg/ml,结核抗体实验(-),PPD试验(-)。心电图提示心房扑动,心室率140次/min,V2~V5导联ST段压低;超声心动图提示左心房扩大,室壁运动普遍减低,左心室射血分数46%,室间隔处二尖瓣环e′值12 cm/s,侧壁处二尖瓣环e′值8.46 cm/s。胸部CT提示心包不均匀增厚伴钙化,双侧胸腔积液,双下肺膨胀不全,两侧胸壁软组织水肿(图1),腹部超声提示肝大,肝中静脉和下腔静脉增宽,符合肝淤血表现,少量腹腔积液。入院后诊断缩窄性心包炎,于全麻下行心包剥脱术。病理提示心包明显增厚,有多量浆细胞、淋巴细胞浸润,有淋巴滤泡形成,纤维组织增生伴玻璃样变性,可见纤维素渗出,免疫组化结果:CD138(浆细胞+),CD38(浆细胞+),IgG1(+),IgG2(+),IgG3(+),IgG4(>20/HPF),CD20(B细胞+),CD3(T细胞+),CD4(T细胞++),特殊染色结果:弹力(+),诊断为IgG4相关性缩窄性心包炎(图2、图3)。术后患者心律转为窦性,症状明显改善,嘱患者出院后继续糖皮质激素治疗,但患者未服用激素治疗。






目前研究发现,IgG4-RD可累及多个器官,但心包炎作为本病的罕见类型较少报道。本病例中,患者术前临床诊断为缩窄性心包炎,但既往无结核病史,血清结核抗体及PPD试验均阴性,没有足够的理检查结果诊断为IgG4相关性缩窄性心包炎,在行心包剥脱术后临床症状明显好转,未发现其他器官或腺体受累,未给予激素治疗,随访2年未发现新的症状,无其他脏器受累。我们复习了Pubmed中的IgG4相关性心包炎的个案报道,见表1。

IgG4相关性心包炎的病例特点
IgG4相关性心包炎的病例特点

注:a为仅有英文摘要;b为支气管哮喘、主动脉瘤,腹膜后纤维化引起的肾积水、肺间质纤维化、硬化性慢性胰腺炎(病理记录)多克隆高球蛋白血症、嗜酸性粒细胞增多症;/为资料不详或缺乏
如上表所示,文献中可确定的IgG4相关性心包炎患者共21例,发病年龄为29~83岁,平均63.9岁,男女比例为15∶6。症状以呼吸困难及双下肢水肿多见,病程长短不一,多数在数周至数月之间。可合并或不合并其他腺体自身免疫性疾病、瘤样包块、淋巴结肿大和后腹膜纤维化等。多数病例CT表现有心包增厚、积液、缩窄等直接表现,可合并心包钙化,明确诊断多数需病理结果,个别案例仅有细胞学结果或影像学结合血清免疫蛋白分类IgG4升高即可诊断。多数病例行心包手术治疗后好转,如临床表现主要由心包积液或缩窄引起,多数患者预后良好,在行心包剥脱术及应用糖皮质激素治疗后明显好转,部分病例未行心包剥脱术,仅激素治疗即可好转。
IgG4-RD的报道多与腺体相关,主要累及胰腺、泪腺、唾液腺、垂体和胆管等组织[3]。IgG4-RD的概念来源于对自身免疫性胰腺炎的研究。2001年,有研究发现自身免疫性胰腺炎的患者胰腺组织中有大量IgG4阳性浆细胞浸润并伴多灶性纤维硬化性改变,且常合并肾脏、唾液腺、泪腺、胆管、腹膜后组织等多器官和组织病变,进而推测胰腺可能只是某种系统性疾病当中的器官损害之一[1]。2010年,具有血清高IgG4水平,组织器官中IgG4阳性浆细胞浸润及多灶性纤维硬化性改变等特点的疾病被命名为IgG4相关性疾病[26]。
IgG4-RD是一种系统性疾病,不同地域和种族间发病率的差异尚待进一步证实,缺乏大样本的流行病学调查。国内有关心包炎的病因分析中较少提到IgG4-RD[27]。IgG4-RD确切的发病机制尚不明确。临床诊断主要是多方面综合判断的结果,组织病理学检查是最重要的诊断方法。IgG4-RD患者血清IgG4可升高,但血清IgG4水平不是诊断该病的高特异性和高敏感性指标,需结合临床表现、影像学特点、血清学检查、组织活检等综合考虑。目前国际公认的诊断标准是日本的IgG4-RD诊断指南,包括3个分类标准:(1)1个或多个脏器的特征性的弥漫性肿胀或团块状病变;(2)血清IgG4水平≥135 mg/dl;(3)组织病理可见密集淋巴浆细胞浸润和席纹状纤维化、闭塞性静脉炎,且IgG4+浆细胞>10个/HP(或IgG4+浆细胞占浆细胞总数的比例>40%)。如符合上述3条,则可确定诊断;仅符合(1)+(3),很可能诊断;符合(1)+(2),可能诊断。诊断时要除外干燥综合征、原发性硬化性胆管炎、多中心Castleman病、炎症性肠病、结节病、淋巴瘤等,有时鉴别很困难,需要活检以明确;对于不适用上述器官非特异性的广泛诊断标准的患者,可以应用器官特异性的诊断标准。若符合器官特异性的IgG4-RD,如自身免疫性胰腺炎类型,腹膜后纤维化、IgG4相关肾病等,即使不满足分类诊断标准亦可诊断[28]。
通过对本例病例的回顾及文献复习,提示我们临床中对于存在IgG4-RD的患者应警惕可累及的众多器官组织,包括心血管系统及心包疾病。另一方面,与本例近似的患者也可能没有其他系统的表现而仅表现为心包缩窄,了解这一疾病并积极通过无创检查确诊并治疗,无疑会使我们临床诊断治疗的水平提高,同时造福患者。
IgG4-RD尚无统一治疗方案,目前公认的治疗首选糖皮质激素且多数患者对糖皮质激素治疗反应良好,但需在尽可能排除胰腺癌、胆管癌等肿瘤可能的前提下应用糖皮质激素。
无